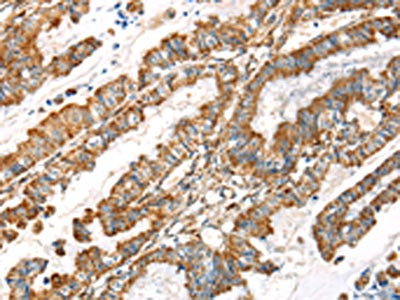

LOXL4 Antibody
-
中文名稱:LOXL4兔多克隆抗體
-
貨號:CSB-PA567337
-
規(guī)格:¥1100
-
圖片:
-
其他:
產(chǎn)品詳情
-
Uniprot No.:
-
基因名:LOXL4
-
別名:4833426I20Rik antibody; FLJ21889 antibody; LOX L4 antibody; LOXC antibody; LOXL 4 antibody; LOXL4 antibody; LOXL4_HUMAN antibody; Lysyl oxidase homolog 4 antibody; Lysyl oxidase like 4 antibody; Lysyl oxidase like protein 4 antibody; Lysyl oxidase related C antibody; Lysyl oxidase related protein C antibody; Lysyl oxidase-like protein 4 antibody; Lysyl oxidase-related protein C antibody
-
宿主:Rabbit
-
反應(yīng)種屬:Human
-
免疫原:Synthetic peptide of Human LOXL4
-
免疫原種屬:Homo sapiens (Human)
-
標(biāo)記方式:Non-conjugated
-
抗體亞型:IgG
-
純化方式:Antigen affinity purification
-
濃度:It differs from different batches. Please contact us to confirm it.
-
保存緩沖液:-20°C, pH7.4 PBS, 0.05% NaN3, 40% Glycerol
-
產(chǎn)品提供形式:Liquid
-
應(yīng)用范圍:ELISA,IHC
-
推薦稀釋比:
Application Recommended Dilution ELISA 1:2000-1:5000 IHC 1:25-1:100 -
Protocols:
-
儲存條件:Upon receipt, store at -20°C or -80°C. Avoid repeated freeze.
-
貨期:Basically, we can dispatch the products out in 1-3 working days after receiving your orders. Delivery time maybe differs from different purchasing way or location, please kindly consult your local distributors for specific delivery time.
-
用途:For Research Use Only. Not for use in diagnostic or therapeutic procedures.
相關(guān)產(chǎn)品
靶點詳情
-
功能:May modulate the formation of a collagenous extracellular matrix.
-
基因功能參考文獻(xiàn):
- study describes for the first time a direct link between a retinoic-induced gene and protein, LOXL4, and its general clinical pro-healing properties in ECM dynamics PMID: 27597564
- Although expression of LOXL4 is not statistically associated with neck metastases, we showed that LOXL4 expression significantly increased in laryngeal cancer. PMID: 26138381
- In hepatocellular carcinoma, low LOXL4 expression was associated with lower overall survival rates and higher cumulative recurrence rates. PMID: 26097573
- These results provide a set of the essential genes in this newly identified miR-193a-3p/LOXL4/Oxidative Stress axis. PMID: 25311867
- High Lysyl oxidase-like 4 promotes proliferation and metastasis of gastric cancer via FAK/Src pathway. PMID: 25216702
- data suggest that abnormal expression of LOXL4 of KCOT may enhance angiogenesis in KCOT, which may help to promote the locally aggressive biological behavior of KCOT. PMID: 24357854
- TGF-beta1 induced injured MCL to express more LOXs than injured ACL (up to 1.85-fold in LOX, 2.21-fold in LOXL-1, 1.71-fold in LOXL-2, 2.52-fold in LOXL-3 and 3.32-fold in LOXL-4). PMID: 23357697
- Alternatively spliced lysyl oxidase-like 4 isoforms have a pro-metastatic role in cancer. PMID: 22806361
- The human lysyl oxidase-like 4 gene does not confer increased genotypic risk for adolescent idiopathic scoliosis. PMID: 21740577
- SNPs in the lysyl oxidase-like protein 4 and complement component 3 genes are associated with increased risk for endometriosis and endometriosis-associated infertility in a Puerto Rican population. PMID: 21733505
- Overexpression of the lysyl oxidase-like 4 gene is associated with metastatic head/neck carcinoma. PMID: 21115907
- The data presented in this work might emphasize the involvement of LOXL4 in molecular processes of the genesis or progression of head and neck carcinomas. PMID: 12894545
- LOXL4, with the four scavenger receptor cysteine rich domains, may also function as an active amine oxidase PMID: 14551188
- Up-regulation of lysyl oxidase mRNA and protein expression is associated with oral squamous cell carcinoma PMID: 17671119
- LOXL4-DC stimulated T cells produce higher IFN-gamma secretion compared to unstimulated T cells and T cells stimulated with untransfected DCs, in the presence of the pan-DR-epitope (PADRE) PMID: 18202753
- These results suggest that LOXL4 may function as a negative feedback regulator of TGF-beta1 in cell invasion by inhibiting the metabolism of extracellular matrix (ECM) components. PMID: 18586005
- Functional analysis of the 5' flanking domain of the LOXL4 gene in head and neck squamous cell carcinoma cells. PMID: 18949373
- In breast carcinoma, LOXL4 was expressed only in the effusion samples. In malignant mesothelioma, LOXL4 and its splice variants were expressed at all sites. PMID: 19015874
顯示更多
收起更多
-
亞細(xì)胞定位:Secreted, extracellular space.
-
蛋白家族:Lysyl oxidase family
-
組織特異性:Expressed in many tissues, the highest levels among the tissues studied being in the skeletal muscle, testis and pancreas. Expressed in cartilage.
-
數(shù)據(jù)庫鏈接:
Most popular with customers
-
-
YWHAB Recombinant Monoclonal Antibody
Applications: ELISA, WB, IHC, IF, FC
Species Reactivity: Human, Mouse, Rat
-
-
-
-
-
-